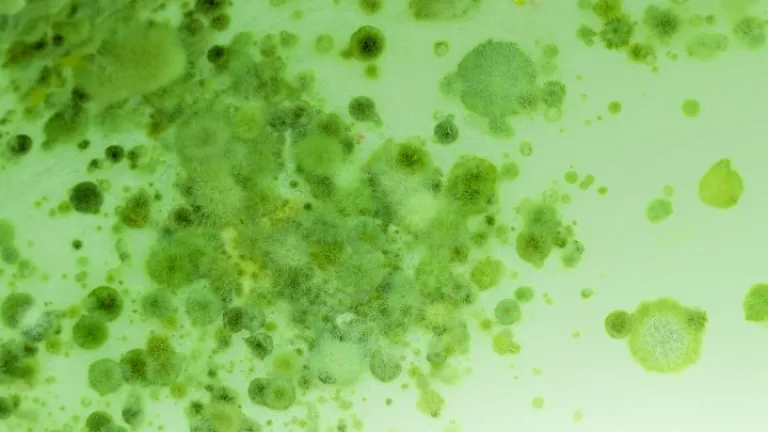
Jesucristo advirtió que, antes de su regreso, "habrá pestes, y hambres, y terremotos en diferentes lugares. Y todo esto será principio de dolores".

Epidemias en la profecía bíblica

La Palabra de Dios predice eventos catastróficos, incluyendo epidemias de enfermedades, en el periodo que precede el regreso de Jesucristo. ¿Está la actual pandemia de coronavirus relacionada con la profecía bíblica?
El amanecer del año 2020 parecía muy esperanzador y prometedor. Obviamente había los acostumbrados lugares y líderes problemáticos en el mundo, pero en general las cosas parecían bastante positivas.
Sin embargo, prácticamente de la noche a la mañana, las condiciones cambiaron dramáticamente. Empezaron a surgir preocupantes informes de China sobre un nuevo virus que había pasado de los animales a los seres humanos, similar a las anteriores gripes transmitidas por los cerdos y las aves. En muchos sentidos, este nuevo o “inusual” coronavirus parecía similar a los virus del resfriado común y la gripe. Pero este era diferente.
Dado que este virus se originó en animales, probablemente murciélagos, y luego mutó y pasó a los seres humanos, los nuevos huéspedes humanos infectados por este virus no tenían inmunidad o defensas naturales contra él.
Inicialmente China, y luego la Organización Mundial de la Salud (OMS), restaron importancia a la amenaza de la propagación entre humanos. Pero el peligro pronto se hizo demasiado grande como para ignorarlo. En efecto, podía propagarse de persona a persona, y a diferencia de los resfriados y gripes normales, las tasas de transmisión y muerte de este virus parecían ser mucho más altas. Los ancianos en particular parecían ser propensos a infecciones pulmonares mortales. El número de muertes se incrementó rápidamente en cientos, y luego miles.
China pronto cerró Wuhan, el epicentro de la epidemia, prohibiendo todo el tráfico de entrada y salida de la ciudad. A sus 11 millones de residentes se les ordenó permanecer en su interior. Poco después, otras ciudades con millones de habitantes fueron cerradas de manera similar. A finales de enero, la Organización Mundial de la Salud había revertido su enfoque y declarado una emergencia sanitaria mundial.
En retrospectiva, esto indudablemente fue demasiado poco, demasiado tarde. En pocas semanas el virus Covid-19 se había extendido por gran parte del mundo, antes de que la mayoría de la gente tuviera siquiera la más mínima idea de lo que estaba sucediendo. La propagación de la epidemia se vio muy favorecida por el hecho de que los gobiernos tardaron en interrumpir los viajes internacionales, gran número de personas infectadas no mostraban signos de enfermedad, el período de incubación era hasta de dos semanas, nadie estaba seguro de cómo se contagiaba el virus, y no se conocía ninguna prueba de detección o tratamiento.
Lamentablemente, ni los gobiernos ni los hospitales de todo el mundo estaban preparados para la explosiva afluencia de pacientes, a pesar de las repetidas advertencias anteriores sobre la probabilidad de una pandemia de este tipo.
Las pandemias y la profecía bíblica
Las pandemias (epidemias globales) han estado con nosotros durante mucho tiempo. El Covid-19 es simplemente la última. Mañana podríamos ver fácilmente el surgimiento, aparentemente de la nada, de otra plaga mucho más severa capaz de arrasar el mundo y dejar a su paso miseria y millones de muertos.
¿Cómo encaja todo esto con la profecía de la Biblia? ¿Arroja alguna luz la profecía bíblica sobre nuestras condiciones actuales y lo que podríamos esperar en el futuro?
Poco antes de su crucifixión, los discípulos de Jesús le preguntaron qué “señales”, sucesos o tendencias precederían su regreso. En respuesta, él mencionó el engaño religioso, las guerras, hambrunas y pestilencias. Dijo que “todo esto será principio de dolores” (Mateo 24:5-8, énfasis nuestro en todo este artículo).
Esto conduciría a lo que comúnmente se llama la gran tribulación, un tiempo de “más angustia que en cualquier otro momento desde el principio del mundo. Y jamás habrá una angustia tan grande”. Y enseguida añadió: “De hecho, a menos que se acorte ese tiempo de calamidad, ni una sola persona sobrevivirá; pero se acortará por el bien de los elegidos de Dios” (Mateo 24:21-22, Nueva Traducción Viviente).
Contemplar esto es verdaderamente aleccionador. ¿Podría la humanidad realmente enfrentarse a una época en la que todos los seres vivos de la Tierra corran peligro de extinción? (En realidad, esa posibilidad ya es un hecho debido a las capacidades de guerra nuclear, química y biológica existentes en el planeta).
Los cuatro jinetes del Apocalipsis
La profecía de Jesús en Mateo 24 es un bosquejo básico de las tendencias y acontecimientos del tiempo del fin. Él entregó una profecía mucho más detallada en el libro del Apocalipsis, cuyo primer versículo dice ser “la revelación de Jesucristo”.
En Apocalipsis 6 encontramos la repetición de las mismas cuatro tendencias principales que Jesús predijo en Mateo 24: engaño religioso, guerra, hambrunas y pestilencias.
El primer jinete, en el versículo 2, está montado en un caballo blanco. Algunos suponen que es Jesucristo, ¡pero no es así! Cristo sí regresa en un caballo blanco, pero no hasta mucho más tarde en la línea de tiempo profética del libro. Este primer jinete empuña un arco y lleva una corona, pero el verdadero Jesús blande una espada y lleva muchas coronas. El primer jinete es un impostor, y representa una religión corrupta y falsa que engañará a la mayoría de la humanidad (ver Mateo 24:5, 11, 24).
El segundo jinete cabalga sobre un caballo bermejo, “y al que lo montaba le fue dado poder de quitar de la tierra la paz, y que se matasen unos a otros, y se le dio una gran espada” (v. 4). Este caballo representa el derramamiento de sangre y el horror de la guerra generalizada que Jesús predijo en Mateo 24:6-7.
Apocalipsis 6:5 describe a un tercer caballo, en este caso negro, cuyo jinete lleva una balanza en la mano. Una voz describe la escasez de comida que afectará a la Tierra después de la guerra. Esto representa las condiciones de hambruna que Jesús predijo en Mateo 24:7.
A continuación se describe al cuarto caballo y su jinete. El apóstol Juan lo describe como “un caballo de color verde pálido. El jinete se llamaba Muerte, y su compañero era la Tumba” (Apocalipsis 6:8, Nueva Traducción Viviente).
The Expositor’s Bible Commentary (Comentario bíblico del expositor) dice esto sobre el color verde pálido del cuarto caballo: “‘Pálido’ (chloros) denota un verde amarillento . . . la palidez de una persona enferma, en contraste con una apariencia saludable”. Para decirlo sin rodeos, este caballo es del color de la muerte, que es el nombre de su jinete.
En la profecía de Jesús registrada en Mateo 24, otra ola de desastres golpeará la Tierra tras el engaño religioso, la guerra y la hambruna: “pestes” o epidemias de enfermedades (versículo 7).
De manera funesta, Juan nos dice en Apocalipsis 6:8 que “le fue dada potestad sobre la cuarta parte de la tierra, para matar con espada, con hambre, con mortandad, y con las fieras de la tierra”.
Y además de la enfermedad vendrán otras plagas. Jesús también mencionó grandes “terremotos” (Mateo 24:7; Apocalipsis 6:12), un término que en el griego original también puede aplicarse a otras calamidades naturales como grandes tormentas y tsunamis.
En medio de tales horrores, las epidemias de enfermedades cobrarán la vida de cientos de millones de personas. En total, ¡la cifra de muertos alcanzará dimensiones que jamás nadie habrá visto!
Para comprender cuán devastadoras y mortales pueden ser estas plagas, repasemos brevemente algunas de las horribles epidemias de nuestro pasado.
Las plagas que cambiaron la historia
En términos de impacto, nada ha igualado a la “peste negra” o “muerte negra” del siglo xiv. Este brote de peste bubónica aparentemente comenzó en Asia y se dirigió hacia el oeste de Europa, donde se propagó rápida y ferozmente. Se cree que mató a un tercio de la población mundial.
Como era típico de las enfermedades de la época, no se conocía ninguna prevención o cura. La estructura social se desmoronó y la población entró en pánico cuando ciudades enteras fueron arrasadas. Las familias fueron diezmadas cuando muchos padres perdieron a sus hijos, niños perdieron a sus padres, y hombres y mujeres perdieron a sus cónyuges.
Sin embargo, esta no era la primera ni la última vez que la plaga marchaba mortalmente a través de la civilización. Ocho siglos antes, en el año 541 d. C., un brote de peste en la época del emperador Justiniano hizo añicos sus sueños de restablecer el poder y la gloria del Imperio romano. Hordas de ratas portadoras de pulgas propagaron la plaga a través del Imperio bizantino, matando alrededor de una cuarta parte de la población mundial, unos 50 millones de personas.
En 1894, otro brote de peste en Hong Kong y Cantón (o Guangzhou) mató entre 80 000 y 100 000 personas, y luego se propagó desde los puertos chinos al resto del mundo, provocando 10 millones de muertes más.
La peste bubónica, sin embargo, está lejos de ser la única asesina en masa cuando se trata de epidemias. En 1817, la primera de las siete pandemias de cólera de los siguientes 150 años comenzó en Rusia y cobró un millón de vidas. El cólera se extendió a la India, donde murieron millones más.
La viruela, la lepra y el sarampión son otras enfermedades que han cobrado millones de vidas. En 1520, la viruela ayudó a derribar al poderoso Imperio azteca en lo que hoy es México.
Hoy en día, los epidemiólogos están muy preocupados por pandemias como la de los virus Covid-19: virus zoonóticos que saltan de los animales a los seres humanos por medio de mutaciones. El VIH es uno de esos asesinos, y ha cobrado unos 35 millones de vidas en los últimos 40 años. El ébola es otro, y mata a sus víctimas tan rápidamente que la mayoría de las veces mueren antes de tener tiempo de contagiar el virus a otros.
Hace poco más de un siglo, una cepa de gripe pasó de las aves a los seres humanos y se estima que cobró 50 millones de vidas durante su mortal marcha alrededor del mundo.
Hoy en día también hay que tener en cuenta la posibilidad, si no la probabilidad, de que se utilicen armas biológicas contra otros seres humanos. La idea ha existido desde el siglo xiv, cuando los invasores mongoles catapultaban cadáveres infestados de plaga sobre los muros de las ciudades para dejar que la plaga matara por ellos. El ántrax y el cólera son solo dos de los numerosos agentes infecciosos mortales que, según sabemos, han sido convertidos en armas biológicas por gobiernos nacionales y por terroristas.
La advertencia de Dios al hombre
El Covid-19 ha llevado a gran parte del mundo prácticamente a un estado de pánico. Naciones enteras han sido cerradas debido a la enfermedad. El cierre de incontables millares de negocios ordenado por los gobiernos ha dejado a millones de personas sin trabajo. Queda por ver si estas medidas están fuera de proporción con el peligro que representa el virus. Sin embargo, el impacto económico de los cierres de empresas puede traer una recesión mundial, si no otra depresión mundial como la de los años treinta.
Sin embargo, estas cosas son solo un anticipo de las catástrofes que vendrán, y que según la profecía bíblica serán muchísimo peores. ¿Podemos imaginar un mundo en el que veamos cientos de millones de muertes?
Esto nos lleva de vuelta al mensaje de Dios a la humanidad a través de los cuatro jinetes. Los horrores que representan –religión falsa, guerra, hambre y enfermedades– son las consecuencias del rechazo de la humanidad a nuestro Creador y de elegir su propia manera de vivir, lo cual, como ha demostrado toda la historia humana, tiene como resultado la muerte (Proverbios 14:12; 16:25).
La Biblia está llena de advertencias y súplicas de Dios para que nos apartemos de nuestros caminos pecaminosos y “[busquemos] al Eterno mientras puede ser hallado” (Isaías 55:6). Él quiere que vivamos con justicia según sus leyes, que nos muestran cómo amarlo él y a nuestro prójimo. Él “no [quiere] que ninguno perezca, sino que todos procedan al arrepentimiento” (2 Pedro 3:9).
El antídoto para las plagas del tiempo del fin
¿Tenemos un antídoto para el cuarto jinete de la enfermedad y la muerte? Sí lo tenemos, y cualquiera de nosotros puede solicitarlo.
Cuando Dios sacó a su pueblo Israel de Egipto, le dijo: “Si ustedes escuchan atentamente la voz del Señor su Dios y hacen lo que es correcto ante sus ojos, obedeciendo sus mandatos y cumpliendo todos sus decretos, entonces no les enviaré ninguna de las enfermedades que envié a los egipcios; porque yo soy el Señor, quien los sana” (Éxodo 15:26, NTV).
Pero si le desobedecían, esto es lo que podían esperar: “Pero si te niegas a escuchar al Señor tu Dios y no obedeces los mandatos y los decretos que te entrego hoy, caerán sobre ti las siguientes maldiciones y te abrumarán . . . El Señor te afligirá con enfermedades hasta acabar contigo en la tierra donde estás a punto de entrar . . . El Señor te castigará con enfermedades degenerativas, con fiebre e inflamaciones . . . El Señor te castigará con locura, ceguera y pánico” (Deuteronomio 28:15, 21-22, 28, NTV).
Sin embargo, después de la devastadora cabalgata de los cuatro jinetes, el libro del Apocalipsis muestra el resto de la historia: la misericordiosa intervención de Dios tanto para corregir como para salvar a la raza humana de la extinción. Dios traerá a la Tierra paz y liberación de la muerte y la enfermedad en su maravilloso reino, pero no antes de que la humanidad haya aprendido la lección de a dónde nos llevan nuestros caminos humanos.
La historia de la humanidad no termina con el último de los cuatro jinetes del Apocalipsis. Juan no vio cuatro jinetes, sino cinco. Y la esperanza de la humanidad radica en el quinto jinete, Jesucristo, cuya cabalgata en Apocalipsis 19:11-16 para intervenir en los asuntos mundiales marca el fin del mal gobierno de la humanidad en la Tierra.
Esta es la verdadera esperanza de la humanidad. Esto, y solo esto, será el verdadero fin de las enfermedades y pandemias mortales. La llegada del Rey de reyes traerá un reino eterno de paz, abundancia y bendiciones para toda la raza humana.
¡Pero usted no tiene que esperar hasta entonces para experimentar las bendiciones que uno puede recibir al conocer y tener una relación con él! ¿Por qué no actuar ahora? ¿Por qué no profundizar en la Palabra de Dios para aprender lo que él realmente quiere y espera de nosotros, y cómo podemos evitar los terribles tiempos que se avecinan en nuestro mundo? ¡La elección depende de usted! BN